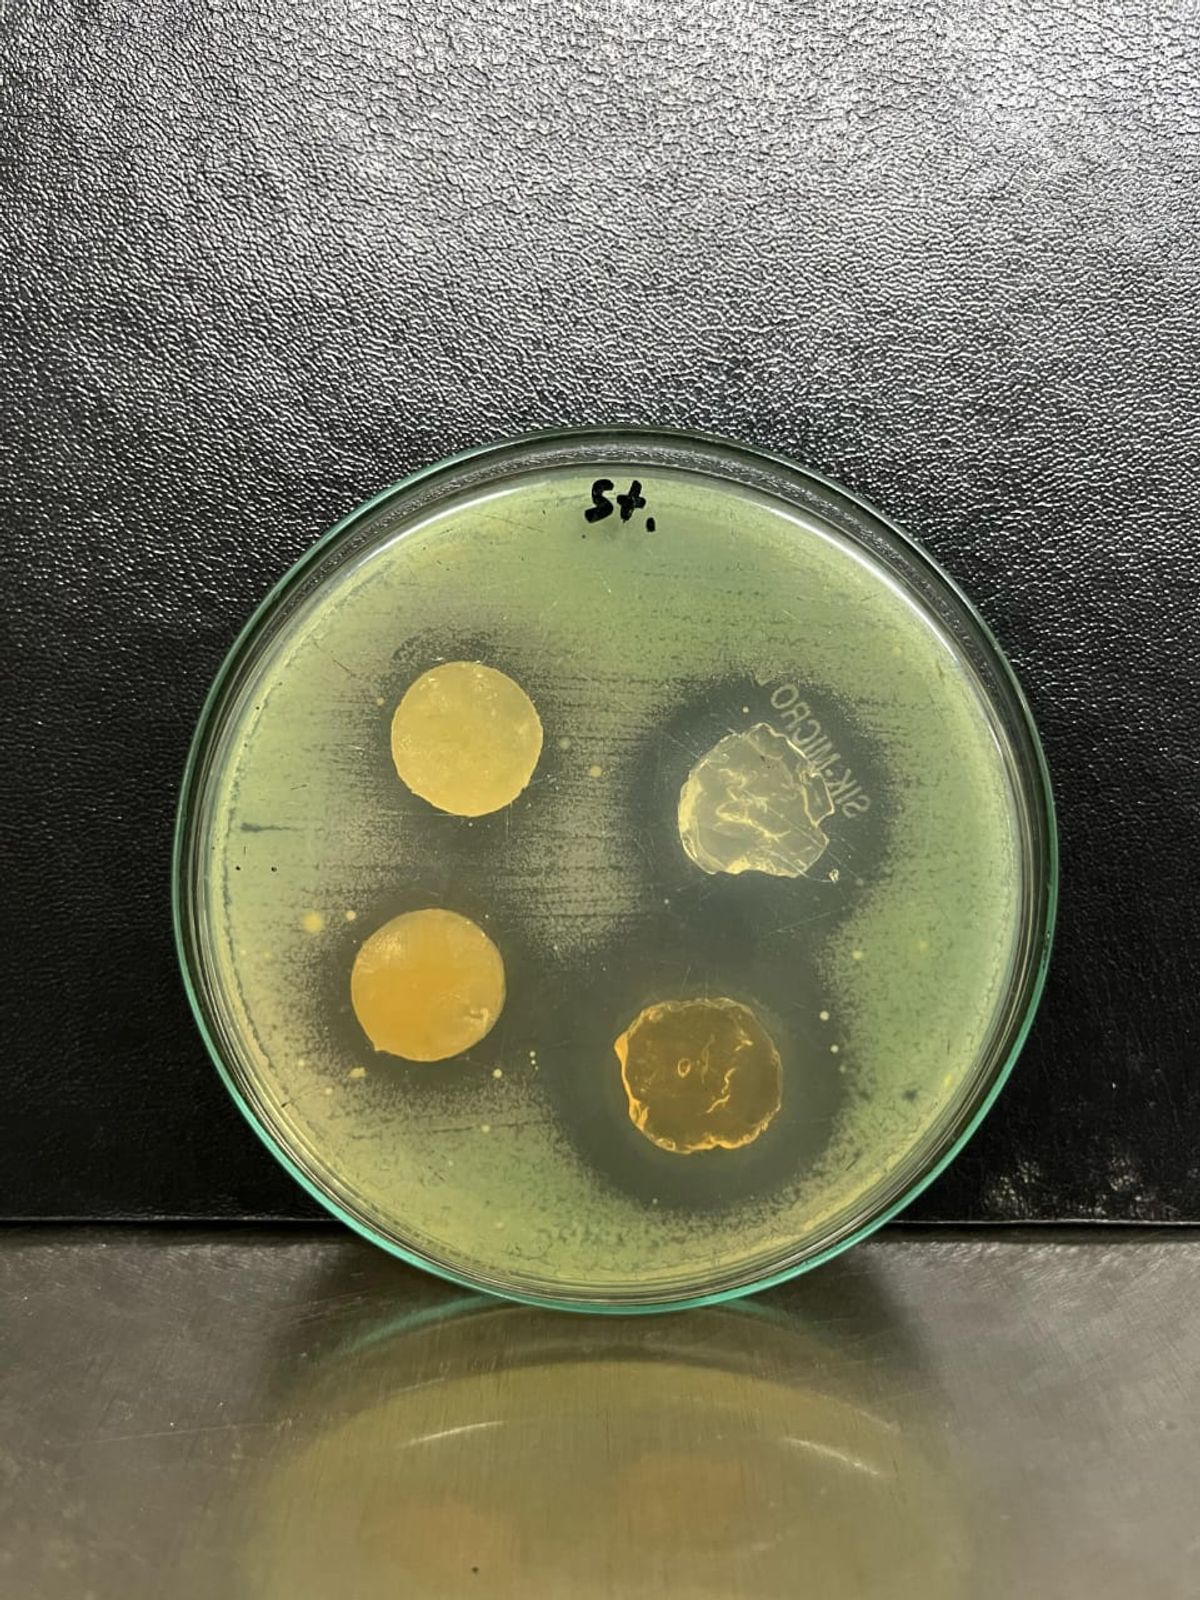

Extraction of cellulose from rice straw and banana stem and fabrication of hydrogel for drug delivery
The present study focuses on the extraction of cellulose from two abundant agricultural wastes—rice straw and banana stem—and its subsequent utilization in hydrogel fabrication for drug delivery applications. Cellulose, being biodegradable, biocompatible, and renewable, offers an excellent polymeric base for designing controlled drug release systems. By processing rice straw and banana stem, cellulose was isolated and chemically modified to form hydrogels with high swelling capacity and porous structures. These hydrogels demonstrate potential as sustainable carriers for therapeutic agents, ensuring gradual and efficient release, thereby contributing to eco-friendly biomedical applications.
Research Images